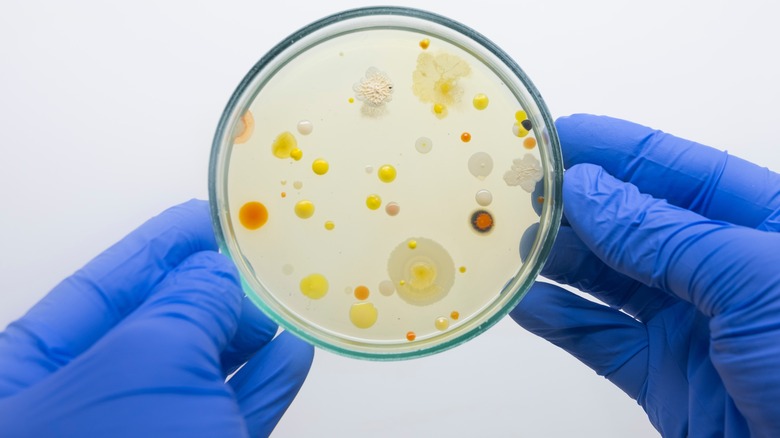

Why May Want To Avoid Using Plastic Trays At Restaurants
CORRECTION 7/8/22: A previous version of this article stated that NSF is short for U.S. National Science Foundation. The two groups are unrelated.
We've been told since we were children to wash our hands before we eat. But just how long before we eat should we be scrubbing down? A study from NSF suggests it could be mere seconds, depending on where you're having your meal.
To conduct the study, which is part of the organization's ongoing Scrub Club hand washing public service initiative, NSF microbiologists took samples from 26 commonly touched surfaces at parks, schools, theaters, restaurants, stores, and medical offices and tested them to see which ones were home to the most germs. While the study notes that germs are not inherently bad, it explains that their presence indicates a hospitable environment for microorganisms including dangerous bacteria and viruses, like influenza, COVID-19, salmonella, or E. Coli, which the Mayo Clinic notes can be incredibly dangerous in restaurants as both are most commonly contracted through contaminated food and can cause severe diarrhea and even life threatening complications. Simply put, the more germs a surface has, the more likely it is that some of those germs could be harmful to people.
After analyzing all of the results, four places ranked as the most germy, containing more than 100 bacteria per square inch, including one which is commonly found in both schools and restaurants.
Unexpected spots for germs
So what is the germiest place in a restaurant? While most people might guess the bathroom or the floor, NSF suggests it's actually plastic cafeteria trays, which are common at buffets, quick service restaurants, and food halls. These findings, which suggested trays contain over 200 bacteria per square inch, corroborate data from Lysol, which named cafeteria trays as the second germiest spots in schools behind bathroom doors. The NSF study suggests that those plastic trays we stack our food on and carry to our tables before digging in have more bacteria than public bathrooms, school bus seats, and virtually anything in a doctor's office. Only three other surfaces in the study were found to have more bacteria: school musical instruments, theater arcade game controllers, and playground sandboxes (which topped the list with a whopping count of 7,440 bacteria, mold, and yeast per gram of sand).
Luckily, most of us don't dine in sandboxes so our biggest concern is those under-washed plastic surfaces in restaurants which previous studies have also shown to include menus, touch screens, and condiment containers (per WebMD). If you work in food service, it might be a good idea to give these oft-overlooked spaces a little bit of extra TLC from time to time as they pass through so many hands, and if you are a diner who can't avoid touching a tray to transport your food, NSF stresses the importance of washing and sanitizing your hands regularly.